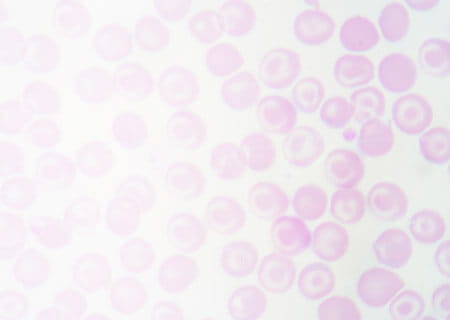

Cancer Diagnosis and Treatment at UH Seidman Cancer Center
At University Hospitals Seidman Cancer Center in Cleveland, Ohio, we are leading the way in the diagnosis and treatment of cancer with state-of-the-art technology that allows our expert care teams to detect tumors earlier, target cancer cells more precisely, and perform complex procedures using minimally invasive techniques. Our patients have access to advanced cancer treatment options, ranging from our pioneering stem cell transplant program and immunotherapy to the first and only proton therapy center in northern Ohio. We also emphasize precision medicine that targets treatment to the unique genomic characteristics of a patient’s tumor.
Diagnosing Cancer
The cancer experts at UH Seidman Cancer Center use a variety of tools to detect and diagnose cancer. Bloodwork and other lab tests, imaging technology (such as CT, MRI, PET and ultrasound) and biopsies are all used to diagnose cancer and determine the cancer’s stage (whether it has spread to other areas of the body.)
UH physicians also have access to state-of-the-art technologies for diagnosing cancer. For example, UH was the first hospital in the U.S. to use a PET/MRI scanner in a clinical setting, which uses positron emission tomography (PET) and magnetic resonance imaging (MRI) technology to generate enhanced digital images and accurately pinpoint cancer locations.
Our specialists use less invasive procedures, specialized state-of-the-art technologies, and other advanced techniques such as molecular biology and genomics in diagnosing cancer. Tools such as this lead to a more precise diagnosis, allowing for more targeted therapies to treat cancer.
Cancer Treatment & Approach
Because each cancer diagnosis and patient is unique, UH Seidman Cancer Center uses an individualized approach when determining and developing your treatment plan. Combining standard therapies with new treatments for cancer, our expert team creates a plan that gives the best chance at successfully treating any type of cancer. Cancer treatment options include:
- Surgery
-
The team of cancer surgeons at UH use the latest surgical techniques to remove the cancer from your body. Some of the state-of-the-art technologies we employ include:
- We were the first cancer hospital in the country to provide an intra-operative MRI Siemens Verio 3.0 Tesla, which allows surgeons to obtain real-time internal images during surgery, helping to ensure that all the cancerous tissue is removed, reducing the need for a second surgery.
- Gamma Knife® Perfexion™ radiosurgery: The most accurate form of stereotactic radiosurgery for the brain
- Breast surgery: Our board-certified surgeons have expertise in all types of breast cancer surgery, including:
- Lumpectomy
- Sentinel node biopsy
- Skin and nipple-sparing mastectomy
- Oncoplastic surgery techniques - Pancreatic surgery: Our experienced pancreas surgeons are highly skilled at performing procedures that can be part of your pancreatic cancer treatment plan, including:
- Whipple procedure (pancreaticoduodenectomy), which removes the right part of the pancreas
- Distal pancreatectomy, which removes the left part of the pancreas
- Total pancreatectomy, which removes the entire pancreas (rare)
- Radiation Therapy
-
Radiation therapy is a very common treatment for cancer, using high-energy particles or waves, such as X-rays, gamma rays, electron beams, or protons, to destroy or damage cancer cells. At UH, we employ some of the most advanced and targeted radiation technologies available today, including:
Proton therapy:
UH is the first in Ohio and the region to offer proton therapy, an advanced form of radiation therapy that precisely targets tumors and can be used to treat both adult and pediatric cancers. - Chemotherapy
-
Chemotherapy is the use of medications to treat cancer. Your physician may prescribe a combination of different drugs to treat your cancer, depending on location and stage of the cancer, as well as other factors. Chemotherapy is often used in conjunction with radiation, surgery and other therapies as part of an overall cancer treatment plan.
- Immunotherapy
-
Immunotherapy, or biological therapy, uses the body’s own immune system to fight cancer. A growing area in cancer treatment, immunotherapy can enhance the body’s ability to recognize and attack cancer cells.
One promising immunotherapy treatment offered at the Wesley Center for Immunotherapy at UH Seidman Cancer Center is CAR T-Cell therapy, which uses the body’s T-cells – a type of white blood cell – to fight cancer. UH is using this FDA-approved immunotherapy to treat certain types of lymphoma and leukemia.
- Cellular Therapy
-
UH Seidman Cancer Center offers advanced stem cell transplant and cellular therapy to treat a range of blood disorders, both cancerous and benign. This includes treatment for leukemia, lymphoma and multiple myeloma, as well as sickle cell disease and aplastic anemia.
- Genomics
-
Genomics is a branch of medicine that analyzes gene sequences in a person’s DNA and uses that information to customize medical care to his or her unique genetic makeup. Because most cancers are associated with damaged or mutated DNA, examining tumor cells at a molecular level can help scientists develop targeted medicines designed to specifically target cancer cells.
- Clinical Trials
-
UH Seidman Cancer Center is dedicated to advancing cancer care through premier cancer research and by offering patients the chance to participate in leading-edge clinical trials. Our clinical trials network has more than 350 open clinical trials, covering many different types and stages of cancer. By participating in a clinical trial, you can access innovative treatments that may not be available at other cancer hospitals.
- Palliative Care
-
The palliative care team at UH Seidman Cancer Center works with you and your family to provide support during your cancer treatment journey. Palliative care focuses on the comfort of the patient, working with the rest of the cancer care team to manage pain and stress, help you navigate the healthcare system, and provide other means of assistance to help improve quality of life.
- Supportive & Integrative Oncology
-
Supportive and integrative oncology focuses on the whole patient, understanding that there is more to cancer care than just treating the physical disease. Supportive oncology brings together a team of caregivers to support you – social workers, spiritual care counselors, mental health experts, dietitians and more. Our integrative oncology team also includes certified art and music therapists to help cancer patients cope with their illness and promote healing of the mind, body and spirit.
Specialty Services, Programs & Cancer Treatment Centers

Stem Cell/Bone Marrow Transplant Program
The UH Seidman Stem Cell Transplant Program provides excellence in transplant care for blood cancer and benign blood disorders.

Proton Therapy Center
We are the first in Ohio and the region to offer proton therapy to treat both adult and pediatric cancers. Proton therapy is a form of radiation therapy that precisely targets tumors.

Breast Health Services
UH provides complete breast health services for women, from breast cancer prevention and screenings to the latest treatments for breast cancer.
Adult Sickle Cell Disease Clinic
Our Adult Sickle Cell Disease Clinic brings together experts from a wide range of specialties to help patients with sickle cell disease.

Cardio Oncology Program
We provide comprehensive cardiovascular care for cancer patients, including monitoring and treating any heart problem before, during or after cancer therapy.

Lung Cancer Screening Program
UH offers a lung cancer screening program for patients who are at high risk for developing lung cancer.

Cancer Care for Babies, Children, Adolescents and Young Adults
The Angie Fowler Adolescent & Young Adult Cancer Institute offers complete cancer care to serve the unique needs of babies, children, teens and young adults with cancer.
Cancer Treatment Clinical Trials
Access to Clinical Trials for the Latest Treatment Options
As a part of the National Cancer Institute-designated Case Comprehensive Cancer Center through Case Western Reserve University, UH Seidman Cancer Center’s team of physician-scientists and clinical researchers are actively involved in more than 350 clinical research trials that are studying and developing new treatments for cancer.
We’re one of seven cancer centers in the country to have access to a pipeline of new drugs through the National Cancer Institute, offering patients newer and better treatment options. Additionally, UH Seidman Cancer Center has established the Developmental Therapeutics Program, in conjunction with the Case Comprehensive Cancer Center, which promotes disease-specific research for developing new cancer drugs.
We continue to participate in early development of FDA-approved drugs for all disease sites. Approximately 20 percent of our patients participate in clinical trials, compared to the national average of 3 to 4 percent.